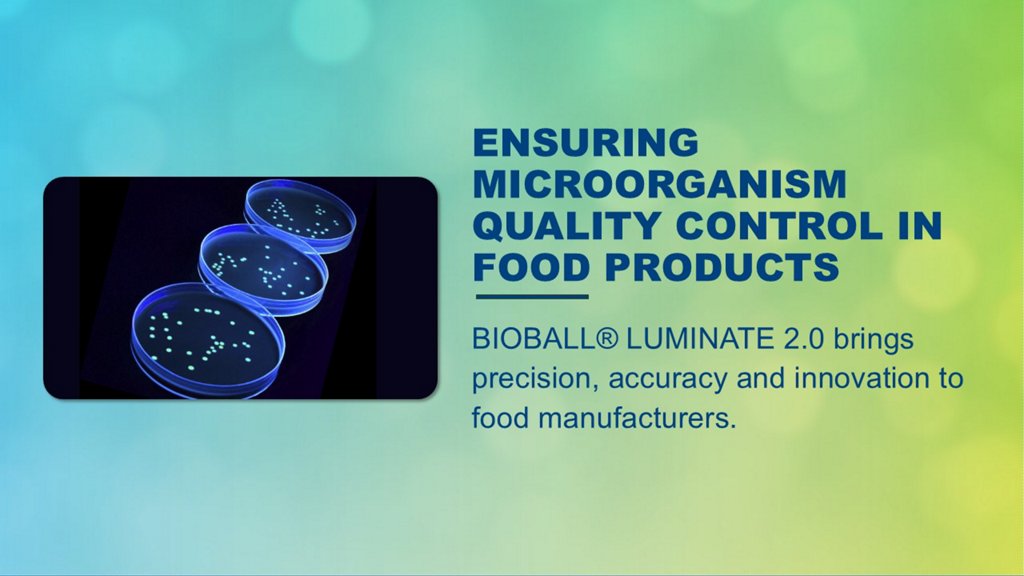

Food Safety & Quality Resources
View the articles below to learn more about the importance of diagnostics in ensuring consumer safety in the Food & Beverage industry.
From webinars, to whitepapers, case studies and other scientific content, we've got you covered!